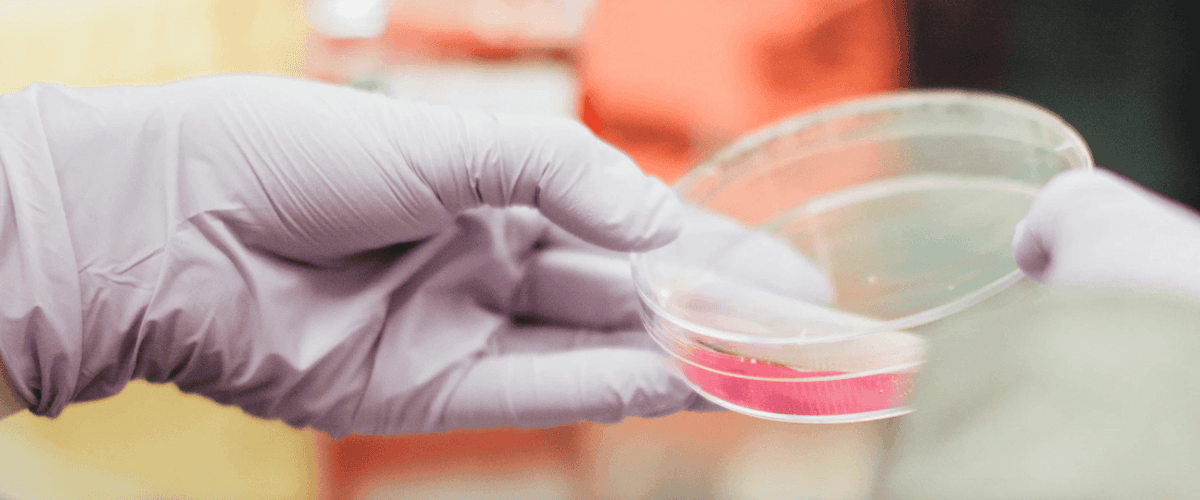
TODO:

Известно, что люди с диабетом 2 типа чаще сталкиваются с формами рака, связанными с ожирением, такими как рак груди, почек, матки, щитовидной железы и яичников, а также с раком желудочно-кишечного тракта, включая рак толстой кишки и поджелудочной железы, и множественной миеломой. Хроническое воспаление, часто встречающееся при ожирении и диабете 2 типа, играет роль в развитии этих заболеваний. Группа ученых под руководством Матильды Дахлин Беннетсен из Центра диабета Стено в Оденсе исследовала, могут ли уровни провоспалительных цитокинов помочь в идентификации пациентов с диабетом 2 типа, которые подвержены повышенному риску рака.
В исследовании приняли участие 6466 человек (40,5% женщин, средний возраст 60,9 лет) из датской когорты DD2, представляющей собой продолжающееся наблюдение за пациентами с недавно диагностированным диабетом 2 типа. Участники были разделены на три группы в зависимости от уровня IL-6 в их крови: низкий (менее 0,94 пг/мл), средний (0,94-1,58 пг/мл) и высокий (более 1,58 пг/мл). В течение медианного периода наблюдения в 8,8 лет у 327 участников развился рак, связанный с ожирением.
Результаты показали, что высокий уровень IL-6 в начале исследования был связан с повышенным риском развития рака, связанного с ожирением. После учета факторов, таких как возраст, пол, длительность диабета, употребление алкоголя, окружность талии, физическая активность, уровень HbA1c, триглицериды и использование лекарств, было установлено, что у пациентов с самым высоким уровнем IL-6 риск развития рака был на 51% выше, чем у тех, кто находился в группе с самым низким уровнем.
Цитокины TNF-альфа и hsCRP показали лишь слабую связь с риском рака по сравнению с IL-6. Включение уровня IL-6 в модель прогнозирования улучшило точность предсказаний развития рака, тогда как добавление TNF-альфа и hsCRP этого эффекта не дало. Исследователи отметили, что даже незначительное повышение точности прогноза имеет важное значение для практики раннего обнаружения и мониторинга раковых заболеваний.
Матильда Дахлин Беннетсен подчеркнула важность регулярных медицинских осмотров и эффективного лечения диабета, отметив, что поддержание здорового образа жизни и следование рекомендациям врача снизит риск развития рака. Она также добавила, что для подтверждения эффективности анализа крови в выявлении пациентов с высоким риском необходимы дальнейшие исследования.